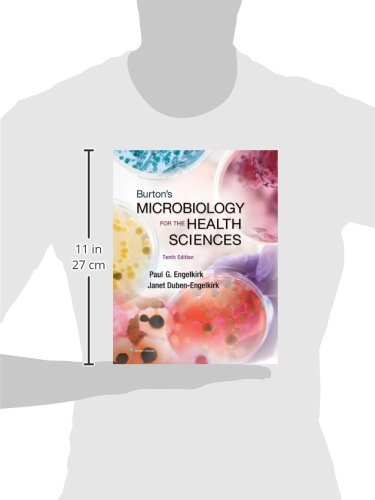
Thumbnail 3

BURTON'S MICROBIOLOGY FOR THE HEALTH SCIENCES 10E: .
A**E
Book for school
Bought this book for my microbiology class from the seller, The Wisdom Shop. Book is used - like new as advertised. No spine issues or front/back cover damage. The book still had the access code on the inside cover, as described, which I needed since my class is an online class.I ordered the book on Jan 10, chose expedited shipping and received it today, Jan 14. Thank you for a great experience buying this book, especially for the price and shipping. 10/10 recommend.In my opinion, the book itself, is not worth $120 brand new from my schools bookstore because it’s a paperback book, a smaller sized book and not the recent edition, but got a great deal on it and it was required.
R**N
😍😍
such an informative read!! i absolutely LOVED reading this before going to bed 😌
A**N
Textbook
I used the ISBN number to make sure it was the correct textbook and it is .
O**S
It said in good condition.
It said in good condition but it came as if it was new, soo good deal.
J**R
Five Stars
I really love the style of this textbook!! My teacher just didn’t stick to it.
A**A
Great informational/educational source!
I absolutely love this book. Microbiology is so fun, and this book makes it easy to understand.
M**A
Learning microbiology specially in the medical field
It is simple to read and came in very condition
N**M
Great book
Great book
A**R
Four Stars
As expected, just really expensive, because students are often bursting at the seams with disposable income.
Trustpilot
3 weeks ago
1 month ago
3 weeks ago
3 weeks ago